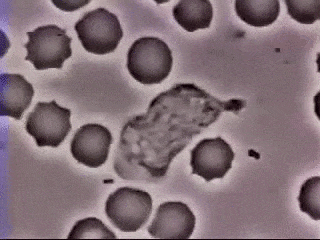

Diseñan moléculas que podrían combatir infecciones causadas por bacterias
Una amenaza a nivel mundial que tendría solución.
Una amenaza a nivel mundial que tendría solución.
En reportes recientes de la Organización Mundial de la Salud (OMS) se describe la importancia de buscar moléculas activas no convencionales que contrarresten la resistencia antimicrobiana, ya que esta problemática se considera como una amenaza creciente para la salud en todo el mundo.
Al respecto, Héctor Manuel Pineda, magíster en Ciencias - Química de la Universidad Nacional de Colombia (UNAL), afirma que la mejor actividad en las cepas evaluadas espera ser una alternativa viable para generar nuevos péptidos antibacterianos sintéticos, promisorios para el desarrollo de nuevas opciones terapéuticas.
En su estudio, el magíster encontró que las 10 quimeras, o uniones de péptidos de las dos especies, presentaron mayor actividad que los dos péptidos por separado.
También halló cuatro secuencias que tienen un amplio espectro de actividad, es decir que son capaces de combatir tanto cepas grampositivas como gramnegativas: “hasta el momento no se habían obtenido péptidos con actividad sobre cepas grampositivas, resistentes a ser combatidas por este tipo de moléculas”, comenta.
Otro resultado importante es que se evaluó el efecto hemolítico en sangre: “vimos que los péptidos usados no atacan los glóbulos rojos humanos, es decir que la actividad es selectiva”, comenta el magíster.
¿Cómo fue la investigación?
Para la investigación se evaluaron secuencias quiméricas o procedentes de dos especies diferentes que contenían péptidos de lactoferricina bovina, presente en la leche y en otros fluidos de la vaca, y que tienen actividad antibacteriana, antifúngica y anticancerígena; también se observaron secuencias de buforina, presente en el sapo asiático Bufo gargarizans, cuya característica principal es la inhibición de la reproducción celular.
El magíster explica que se realizaron varios diseños de secuencias quiméricas, como por ejemplo la unión química de las dos secuencias mencionadas sin ningún tipo de modificación, o la unión de estas incluyendo otras moléculas no naturales.
¿Cuál fue el proceso del estudio?
La primera etapa consistió en diseñar y obtener quimeras peptídicas mediante síntesis de péptidos en fase sólida (SPPS), que en total fueron nueve. Además se implementó la química click, proceso que se usó para unir péptidos cortos de forma rápida y fiable con el fin de obtener secuencias más grandes.
En la segunda etapa se evaluó la actividad antibacteriana en cepas de E. coli, S. aureus, E. faecalis y P. aeruginosa.
En la tercera fase del estudio se evaluó el comportamiento de los péptidos diseñados a lo largo del tiempo frente a las cepas mencionadas.
¿Cuál fue el resultado?
Se encontró que las secuencias presentaron un efecto bactericida.
Para el investigador, los péptidos antimicrobianos surgen como candidatos a nuevos agentes terapéuticos; el diseño de quimeras es hoy una de las estrategias que buscan potenciar la actividad de péptidos antimicrobianos sintéticos, un avance prometedor al que también se le está apostando desde la ciencia y tecnología nacional.